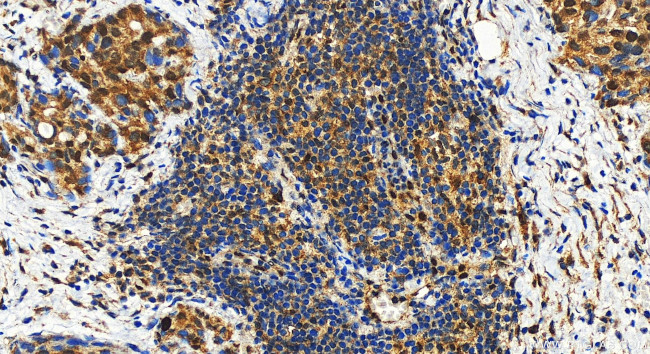
RB1 Antibody in Immunohistochemistry (Paraffin) (IHC (P))

Search
Proteintech
RB1 Polyclonal Antibody
{{$productOrderCtrl.translations['antibody.pdp.commerceCard.promotion.promotions']}}
{{$productOrderCtrl.translations['antibody.pdp.commerceCard.promotion.viewpromo']}}
{{$productOrderCtrl.translations['antibody.pdp.commerceCard.promotion.promocode']}}: {{promo.promoCode}} {{promo.promoTitle}} {{promo.promoDescription}}. {{$productOrderCtrl.translations['antibody.pdp.commerceCard.promotion.learnmore']}}
产品信息
30374-1-AP
种属反应
宿主/亚型
分类
类型
抗原
偶联物
形式
浓度
纯化类型
保存液
内含物
保存条件
运输条件
靶标信息
Rb is a tumor suppressor nuclear phosphoprotein capable of binding to DNA. It is phosphorylated on serine and threonine, but not on tyrosine residues. It forms a complex with SV40 large T antigen, adenovirus E1A, and human papilloma virus-16 E. Rb protein may act by regulating transcription and loss of its function leads to uncontrolled cell growth. Aberrations in the RB gene have been implicated in cancers of breast, colon, prostate, kidney, nasopharynx, and leukemia.
仅用于科研。不用于诊断过程。未经明确授权不得转售。
篇参考文献 (0)
生物信息学
蛋白别名: Cleaved Rb; delta RB-p70; DRb-p70; exon 17 tumor GOS561 substitution mutation causes premature stop; GOS563 exon 17 substitution mutation causes premature stop; p105-Rb; P105RB; p110-RB1; Phospho-Retinoblastoma; pp110; pRb; prepro-retinoblastoma-associated protein; protein phosphatase 1, regulatory subunit 130; Rb; Rb-p70; Retin; Retinoblastoma; retinoblastoma 1; retinoblastoma gene; retinoblastoma suspectibility protein; Retinoblastoma-associated protein
基因别名: OSRC; p105-Rb; pp110; PPP1R130; pRb; RB; RB1
UniProt ID: (Human) P06400
Entrez Gene ID: (Human) 5925